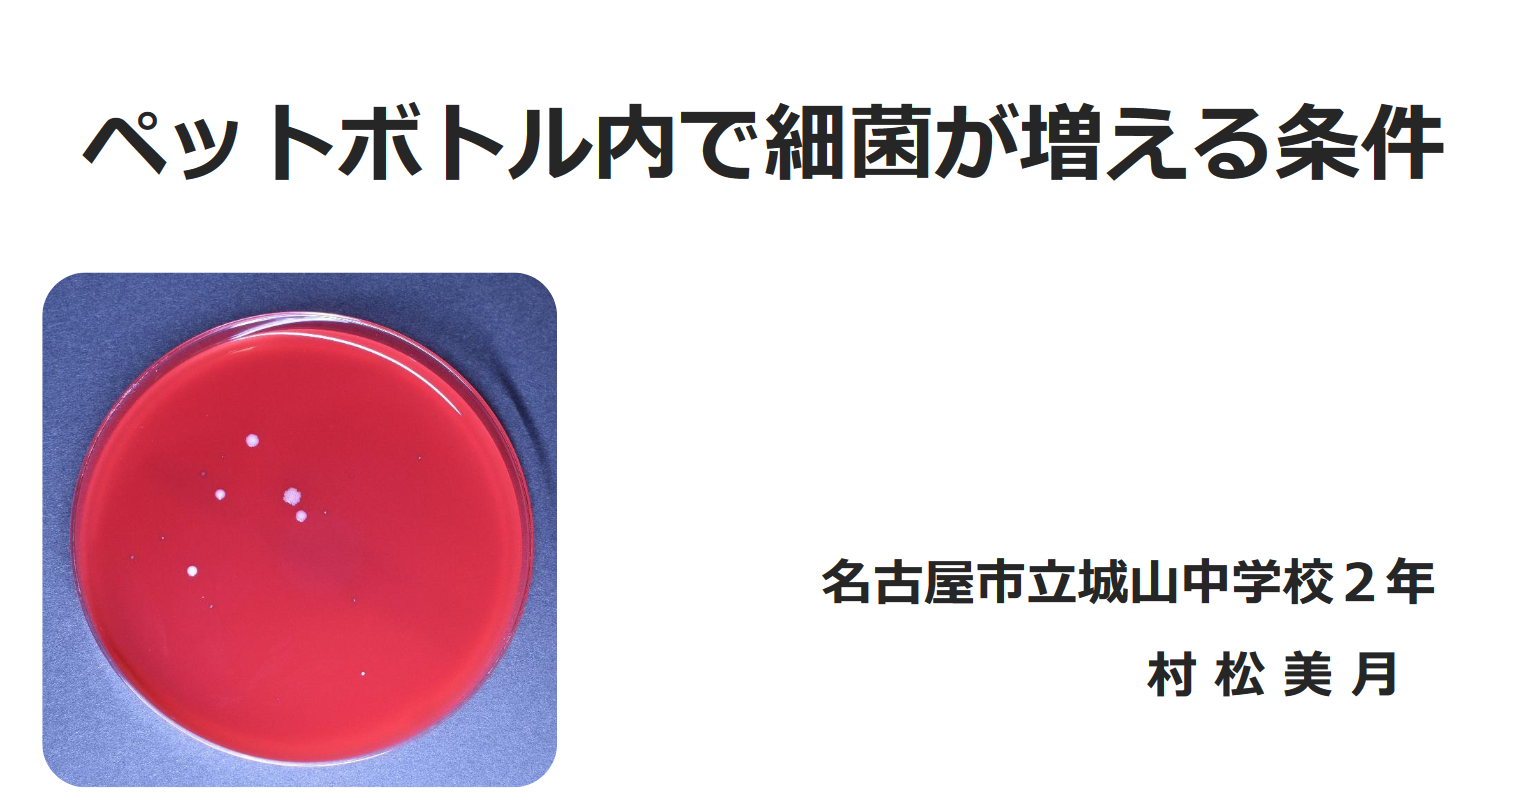

長文
長文 水を注ぐ音とお湯を注ぐ音
水を注ぐ音とお湯を注ぐ音ほんまや全然ちゃうやん pic.twitter.com/ov65QENvWl— 3110 (@3_1_1_0) June 17, 2023 元動画貼っときますので、いいねとチャンネル登録してきてください。「一般に液体...
 長文
長文 長文
長文  長文
長文  長文
長文  長文
長文  長文
長文  長文
長文  長文
長文  長文
長文  長文
長文